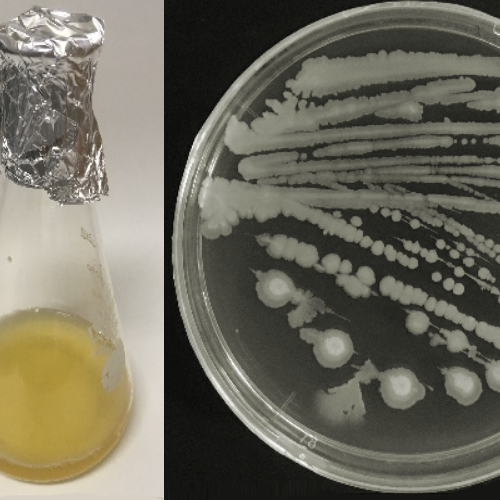
バシラス
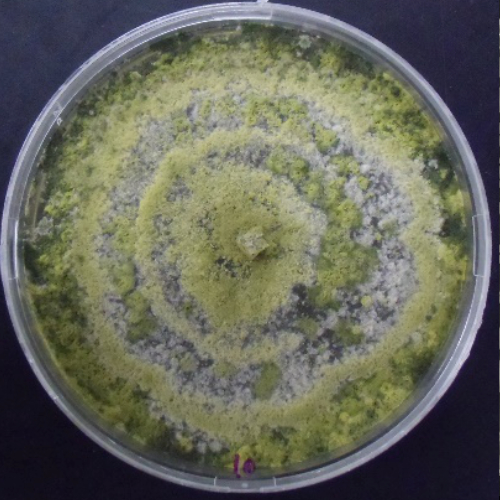
トリコデルマ

Research
研究開発
ホーム >> 研究開発
研究開発について
十和田グリーンタフ・アグロサイエンス株式会社では、十和田石(ヒナイグリーン®)に関する調査・研究、用途開発を大学や研究機関との産学連携を積極的に行い、新たな市場創造を目指しています。

STUDIES
十和田石と菌類の研究
有用細菌の増殖促進効果
Bacillus属細菌の増殖が十和田石の添加により促進されることが明らかになりました。
また、増殖の促進に伴い、植物病原菌を抑える物質の生産も向上しました。
実際に、この細菌の培地に十和田石を0.5%添加すると、増殖が10倍、植物病原菌を抑える物質の生産が5倍増加しました。
このような結果から、十和田石は土壌中の有用微生物の働きを活性化させることが期待されます。
トリコデルマ菌の単離 〜Trichoderma atroviride HNT-01の単離〜
十和田石採掘場の十和田石粉末からT. atroviride HNT-01を単離し、様々な特性を試験しました。
その結果、本菌株は、緑色の胞子形成し、幅広い植物病原菌への抑制効果や植物生長促進に関わる代謝物の生産、ハダニに対する殺ダニ効果などが認められました。
このように本菌株は様々な農業上、多くの有用な活性を持つ微生物であり、現在は、より詳細な研究を行っています。
OTHERS
機能性資材の研究 - 農業資材以外の用途へ
鶏舎内の臭気緩和効果 〜鶏舎内の環境を改善 〜
十和田石を混合した敷料と通常の敷料を用いて比内地鶏の飼育試験(各500羽)を行ったところ、十和田石を混合した敷料の方が、通常の敷料に比べて3〜5℃程度温度が高くなる傾向が認められました。
鶏糞中の微生物が十和田石によって活性化し、その発酵が促進されたものと考えられます。
また、これに伴って鶏舎内の湿度が低く抑えられたり、臭気が緩和されるなど、鶏舎内環境の改善効果が認められました。

河川や湖沼の水質保全効果 〜 酸性土壌や酸性水を中和 〜
十和田石は、特に酸性土壌や酸性水を中和する効果に優れています。
これは 十和田石に含まれているカルシウムが水の中で水素イオンと『イオン交換反応』するためと考えられています。
このような十和田石のpH調整効果は、例えば酸性雨などで酸性化した土壌の改良材や、河川や湖沼の水質保全に応用することが期待されています。



